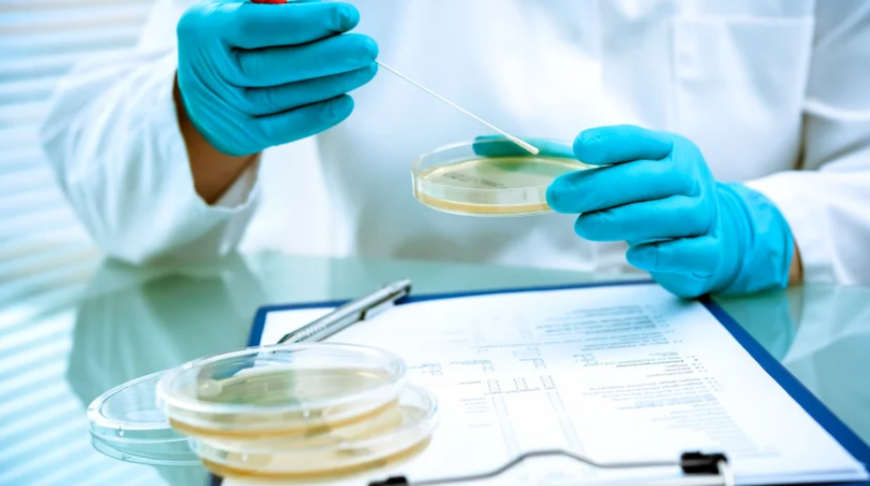
Фот unsplash.com

20 мая, Минск /Корр. БЕЛТА/. Китайские ученые обнаружили на космической станции "Тяньгун" неизвестную бактерию. Она обладает свойствами, помогающими выживать в стрессовых условиях на высоте нескольких сотен километров над поверхностью планеты, сообщает "МИР24".
Новый вид оказался близким родственником Niallia circulans - палочковидной почвенной бактерии, ему присвоили название Niallia tiangongensis. Следы этой бактерии были обнаружены в каюте и поверхности модулей станции в мае 2023 года. Ученые выяснили, что новый вид способен выживать в экстремальных условиях космоса. Он устойчив к окислительному стрессу и может восстанавливать повреждения от радиации. Эти свойства делают бактерию перспективной для использования в космических технологиях, медицине и сельском хозяйстве. Кроме того, микроорганизм умеет разлагать органические соединения, что может помочь перерабатывать отходы в полезные ресурсы как в космосе, так и на Земле.
Исследования показывают, что бактерии легко адаптируются к условиям космических станций. Бороться с ними практически бесполезно. Так, в "чистых" помещениях, которые NASA использовало для подготовки к марсианской миссии "Феникс", обнаружили 26 новых видов микробов. Способность микроорганизмов выживать в условиях, которые люди считают стерильными, обусловлена генами, отвечающими за восстановление ДНК и устойчивость к токсичным веществам. Ученые намерены установить, представляет ли Niallia tiangongensis какую-либо опасность для астронавтов.-0-
Калейдоскоп
20 мая 2025, 14:54
На китайской орбитальной станции нашли неизвестную бактерию
Главное
Топ-новости

- размещаются материалы рекламно-информационного характера.
- размещаются материалы рекламно-информационного характера.